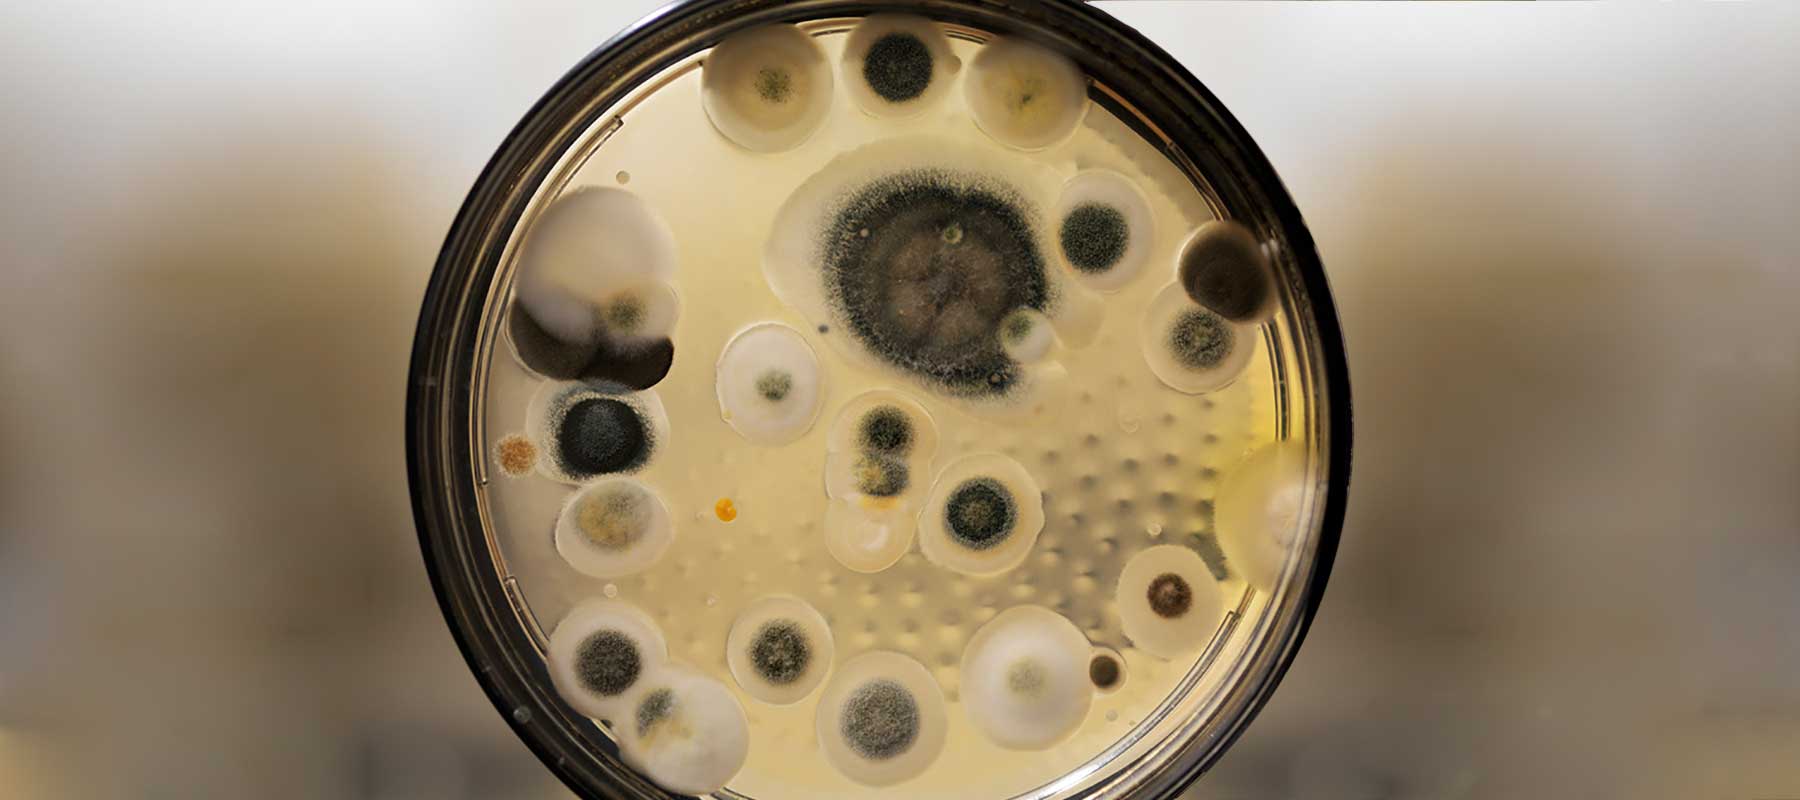

No products in the cart.

FLORIDA MOLD REMEDIATION EXPERTS
HomeCleanse professionals are trained experts in mold remediation and removal in your home or business. We are your Florida mold remediation experts, serving the Orlando and Tampa areas, down to Miami.
Or Call Today!
(407)772-MOLD (6653).
Medically advised, technologically advanced mold remediation.
HomeCleanse is both licensed & certified to perform all aspects of any mold remediation project.
Our Florida mold remediation team follows an advance series of steps in our mold removal process.
Using botanical products, engineering controls, and building science, we remove mold, its by-products and other harmful pollutants, safely and effectively from your home. Our mold remediation and removal process will remove the root cause of your mold issues, not just temporarily cover up the issue.
We’re one of the few companies nationwide that has scientifically been proven, through independent laboratory testing, to remove mycotoxins (a toxic by-product of certain molds).
WHAT ARE MYCOTOXINS?
Mycotoxins are secondary metabolites produced by microfungi that are capable of causing disease and death in humans and other animals. Because of their pharmacological activity, some mycotoxins or mycotoxin derivatives have found use as antibiotics, growth promotants, and other kinds of drugs; still others have been implicated as chemical warfare agents.
OUR FLORIDA MOLD REMEDIATION SERVICE AREA
HomeCleanse primarily serves the Orlando and Tampa areas, and will travel north to Gainesville and south to the West Palm Beach, Fort Lauderdale, Miami metro areas. Unlike traditional mold removal companies, our Florida mold remediation team will remove the root cause of your mold issues, not just temporarily cover up the issue.

DESIGNED TO MEET THE SPECIFIC NEEDS OF OUR CLIENTS.
HomeCleanse continually consults with Mold, Lyme, and Immunosuppressive Specialists in the Florida medical community to create tailor-made product lists for each unique project.
We’re experienced in working with mold related sensitivities and health conditions. Have you been diagnosed?